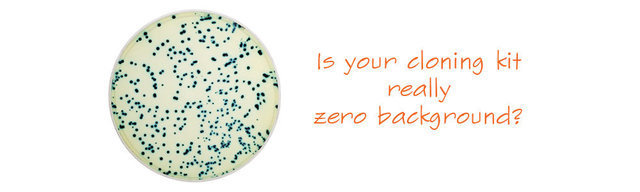
TOPO克隆载体试剂盒-末端加A片段和平末端片段均适用-Am

相关产品推荐更多 >
万千商家帮你免费找货
0 人在求购买到急需产品
- 详细信息
- 文献和实验
- 技术资料
- 库存:
100
- 英文名:
CloneSmarter
- 保质期:
2年
- 供应商:
上海烜雅生物科技有限公司
- 保存条件:
-20℃
- 规格:
50T
载作用载体抗体:Amp
作用:既适用于平末端克隆,又适用于末端加A片段克隆

TOPO克隆技术:1997年诞生的TOPO克隆技术,颠覆了之前的一切,5分钟即可完成连接实验!
Clone Smarter第二代克隆载体:Vaccinia TopoisomeraseI 牛痘病毒拓扑异构酶I特异性识别topo载体 5 ’ -CCCTT-3’序列并形成中间体,与之共价结合的TopoisomeraseI 能将切开的载体片段和具有5’-OH 的DNA片段迅速连接起来
1. 真正做到零背景!载体不会自连!
由于 拓扑异构酶I可以把任何DNA连接起来,所以TOPO载体自连的背景高
但Clone Smarter克服了这一点,该独特技术全球独有!
长的就是对的,无需再次筛选!
2. 高效率( 转化子数更多,阳性率更高, ≥5kb基因仍有95%以上的阳性率)
酶已偶联到载体上,连接效率更高
3. 省时: 连接+转化最快仅5min ( 真正做到长片段连接5min也能保证足够转化子 )
4. 无需蓝白班筛选:载体不含LacZ基因,平板无需涂IPTG和X-Gal( 省时省钱),不会产生“白边蓝芯”克隆菌
5. 操作简单: PCR片段 + TOPO载体 + 增强剂 ,PCR产物无需酶切,室温下连接混匀 时间 ≤5min 即可转化
6. 耐受部分毒性基因:由于载体含有3个终止子,能最大程度降低表达背景,可耐受一些低毒性基因的克隆
7. 原装进口, 超高性价比:按照5ul体系实验,成本不足11元/次!
25次!(10ul体系) 载体浓度高达20ng/ul
( Clone Smarter试剂盒提供的载体量按照110%提供,多提供了10%的优惠量!)
C5855 载体不含酶切位点
风险提示:丁香通仅作为第三方平台,为商家信息发布提供平台空间。用户咨询产品时请注意保护个人信息及财产安全,合理判断,谨慎选购商品,商家和用户对交易行为负责。对于医疗器械类产品,请先查证核实企业经营资质和医疗器械产品注册证情况。
文献和实验表达载体的构建方法及步骤 一、载体的选择及如何阅读质粒图谱 目前,载体主要有病毒和非病毒两大类,其中质粒 DNA 是一种新的非病毒转基因载体。 一个合格质粒的组成要素: (1)复制起始位点 Ori 即控制复制起始的位点。原核生物 DNA 分子中只有一个复制起始点。而 真核生物 DNA 分子有多个复制起始位点。 (2)抗生素抗性基因可以便于加以检测,如 Amp+ ,Kan+ (3)多克隆位点 MCS 克隆携带外源基因片段 (4) P/E 启动子/增强
方法【实验原理】DNA 连接酶可以在两个双链 DNA 分子相邻的 5'-磷酸与 3'-羟基之间形成磷酸二酯键,从而可以实现重组 DNA 分子的构建。一般在连接反应之前,DNA 分子都要进行限制性内切酶消化,使待重组的 DNA 分子具有相匹配的末端,黏性末端连接和平齐末端连接是最常用的,但不匹配的末端也可以经过修饰实现连接。下面以质粒 DNA 为载体,介绍目的 DNA 片段与载体的连接。黏性末端的连接涉及三种情况:①载体和 DNA 片段经双酶切后,两端具有不同的粘端,可以直接进行连接反应。②载体和 DNA
体会有什么不一样?有两种情况:一是两个复制起点适用的宿主细胞不一样,比如说,一个复制起点适合于大肠杆菌,因为大肠杆菌是基因工程中使用频率最高的宿主菌,另一个复制起点适合于另一种细菌或真核生物细胞,那么这种克隆载体常称之为穿梭载体(shuttle vector),换言之,穿梭载体可在两种生物内进行来回的穿梭;另一种情况是同一个载体中的两个复制起点都是适合于一种细胞的,只不过这两个复制起点分别是在一定遗传背景条件下起作用,这种类型的载体多数是属于大肠杆菌的载体。 克隆载体的克隆位点 分子克隆载体
技术资料暂无技术资料 索取技术资料










